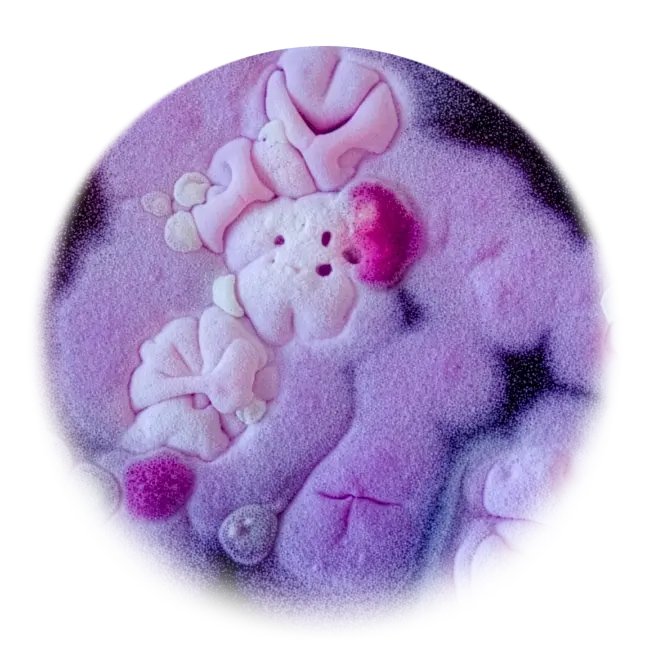

Powering global food innovation
Driving the sustainable protein revolution through science, innovation and collaboration.
Transforming how the world produces, consumes, and thinks about protein.
Supported by the Bezos Earth Fund and UKRI, we unite world-leading researchers, startups, and industry partners to transform how the world produces and consumes protein.
Our vision
Our mission is to complement conventional meat with alternative proteins through five core pillars

Accelerate commercialisation through funding, mentorship and industry partnerships.
Turning breakthrough science into scalable, investable ventures. We support researchers and founders to move sustainable protein innovations from lab to market through structured venture creation and industry collaboration.
- Accelerate from lab to traction. Equity-free funding, mentorship and investment readiness through our Greenhouse programme.
- Connect to capital and leadership. Access to sector-focused VCs and experienced executives via our Food VC Network and CEO Bank.
- Align with real-world demand. Corporate partnerships and hands-on translation support to drive commercial impact.

Fund, support and collaborate on groundbreaking research and innovation.
Advancing sustainable protein innovation through integrated research platforms. We combine fermentation, cultivated meat, plant, algal and hybrid systems to accelerate scalable, nutritious and climate-resilient food production.
- Science-driven innovation at scale. Advancing next-generation protein technologies through integrated biological and engineering research.
- From discovery to deployment. Optimising processes, systems, and products to bridge laboratory breakthroughs with real-world manufacturing.
- Health, sustainability and public confidence. Ensuring alternative proteins deliver strong nutritional value, safety, and consumer trust.

Nurture the leaders of tomorrow via sponsorships, mentorships and talent development.
Building the future workforce in sustainable protein. We train the next generation of scientists, founders, and industry leaders through interdisciplinary education rooted in world-class research and real-world relevance.
- Interdisciplinary excellence with real-world impact. Combining engineering biology, food innovation, and commercial insight to prepare our talents.
- Flexible learning for every career stage. From PhDs and MRes programmes to executive education, bootcamps, and industry-facing short courses.
- Connected to industry and innovation. Direct exposure to startups, investors, corporates, and state-of-the-art laboratories.

Build strategic connections, co-host events, drive impact and inspire collaborations.
Connecting the ecosystem to turn innovation into impact. We convene researchers, ventures, policymakers, educators and industry leaders to shape markets, skills, sustainability and public trust in sustainable protein.
- Build strategic partnerships with purpose. Link science, startups, corporates and regulators to accelerate ventures, enable responsible innovation and strengthen policy pathways.
- Co-host, convene and mobilise. Create forums, roundtables and collaborative programmes that translate shared insight into coordinated action.
- Drive measurable impact together. Inspire cross-sector collaborations that deliver new companies, informed regulation, skilled talent and foods that succeed in the real world.

Share expertise and insights to shape policy, drive industry developments and fuel culinary innovation.
Advancing sustainable protein through shared knowledge and global engagement. We translate scientific insight into practical guidance for policymakers, industry leaders, and innovators shaping the future of food.
- Informing policy and regulation. Providing evidence-based expertise to support balanced, forward-looking food system governance.
- Guiding industry and investment. Sharing technical insight, market intelligence, and strategic foresight to accelerate responsible growth.
- Inspiring culinary and public innovation. Bridging science with chefs, creators, and communities to reimagine how sustainable proteins are understood and experienced.
Partner
Join a thriving ecosystem
We connect startups, corporates, investors, and researchers to accelerate innovation and scale solutions.
Food security is one of the biggest challenges facing humanity. For a sustainable future, we need to ensure that people across the world can be fed adequately and nutritiously with minimal impact on biodiversity, climate and our wider natural environment.

Latest news
real world outcomes
Where science becomes food
Our research powers new ingredients, technologies, and startups that make sustainable protein possible at global scale.